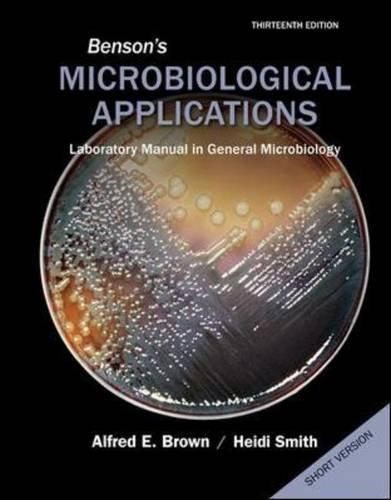

Bensons Microbiological Applications Laboratory Manual In General Microbiology Short Version 13Th Edition
19.99 $
SKU: EB-07385
Category: Books
Related products
Books
19.99 $
19.99 $
19.99 $
19.99 $
19.99 $